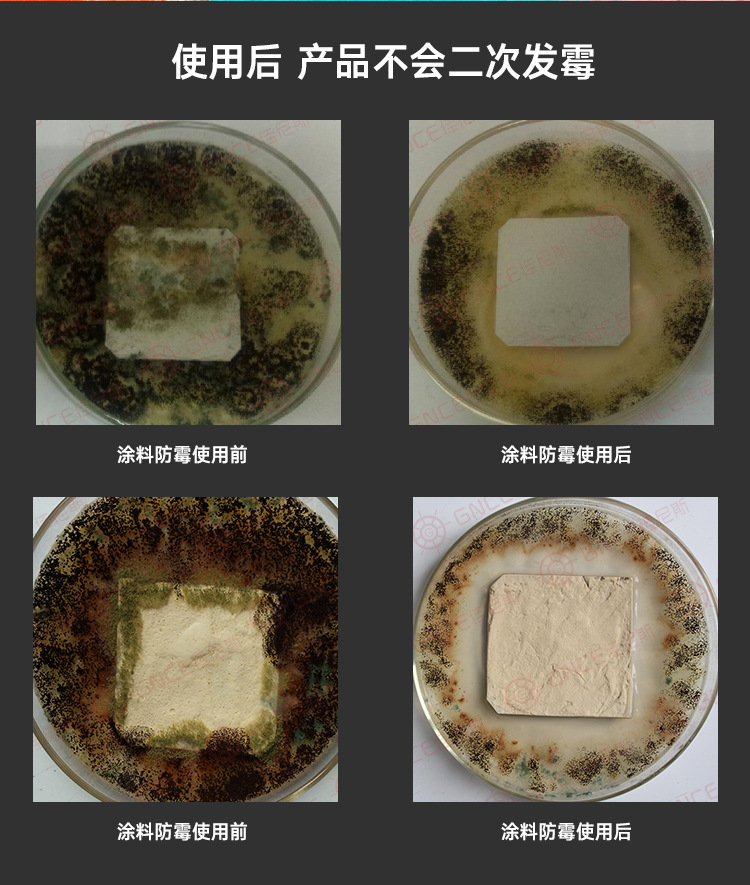

电话:
电话:
020-86532540
 手机:
手机:
18102206864
 邮箱:
邮箱:
yangtao@gnce.cn
 地址:
地址:
广东省广州市花都区狮岭镇新花路21号福野工业园3栋3楼
 微信:
微信:
扫一扫添加技术工程师微信














【产品名称】: 涂料防霉剂 【品 牌】:佳尼斯
【产品型号】: GNCE5700-JS1 【产品形状】: 粉末
【产品颜色】: 白色 【产品包装】: 25KG装
【适用范围】: 适用于硅藻泥、贝壳粉等粉体涂料
涂料为什么要防霉/抗菌?
1在南方和沿海地区的回南天、梅雨时节等潮湿季节 墙壁长霉现象越来越普遍。
2.病人、儿童、老人等体弱人群对细菌的抵抗力弱,容易感染细菌而发病医院、幼儿园、公共场所做抗菌处理越来越普遍
3.21世纪是健康营销的时代,环保无毒涂料大行其道,防霉抗菌涂料作为一种功能性产品,被各大品牌青睐。
防霉专利配方
本产品经过多种霉菌、细菌及药剂的筛选,融合多种防霉剂的特性,能起到很好的防霉效果,更有抗菌功能。经过本产品处
理过的材料,对黑曲霉、绿色木霉、出芽短梗霉具有很好的抑杀作用。
效果更持久
热稳定性好,耐高温,不易变色;
拥有良好的相容性和分散性表面不存在肉眼可见的固体颗粒
防霉抗菌
主要用于控制霉菌,可被用于墙壁粉体涂料类用,以防止墙壁发霉长期保护墙壁,即使潮湿也不会发霉。